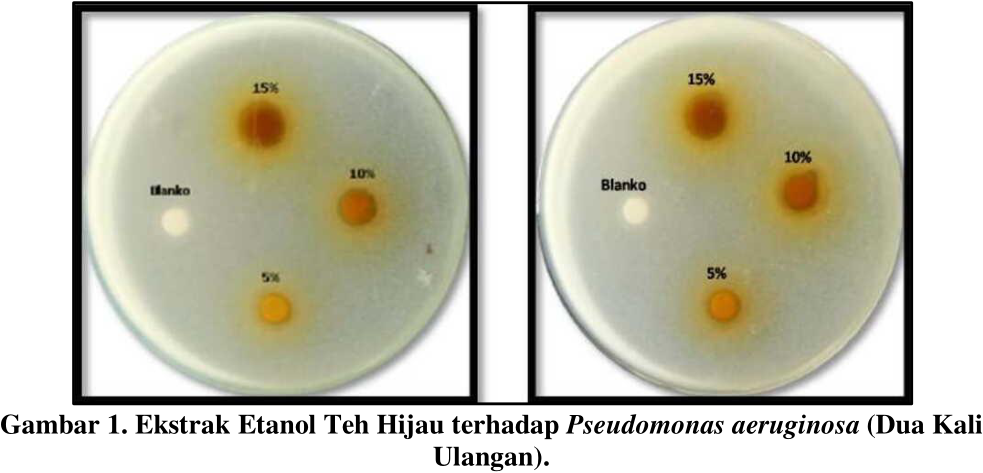

Vol. 2 No. 4 (2022): October
Articles
-
Kompetensi Guru IPA yang Diperlukan untuk Membelajarkan Sains di Indonesia
 DOI :
https://doi.org/10.36312/pjipst.v2i4.121
DOI :
https://doi.org/10.36312/pjipst.v2i4.121
 Abstract View: 713 | Full Paper Download: 965
Abstract View: 713 | Full Paper Download: 965
-
Studi Literatur : Pengaruh Suhu terhadap Ikan Nila (Oreochromis niloticus)
 DOI :
https://doi.org/10.36312/pjipst.v2i4.110
DOI :
https://doi.org/10.36312/pjipst.v2i4.110
 Abstract View: 7815 | Full Paper Download: 15990
Abstract View: 7815 | Full Paper Download: 15990
-
Khasiat Ekstrak Etanol Teh Hijau terhadap Pseudomonas aeruginosa
 DOI :
https://doi.org/10.36312/pjipst.v2i4.125
DOI :
https://doi.org/10.36312/pjipst.v2i4.125
 Abstract View: 922 | Full Paper Download: 826
Abstract View: 922 | Full Paper Download: 826
-
Pengaruh Penambahan Garam Ikan dan Probiotik terhadap Kualitas Air pada Ikan Guppy (Poecilla reticulata)
 DOI :
https://doi.org/10.36312/pjipst.v2i4.126
DOI :
https://doi.org/10.36312/pjipst.v2i4.126
 Abstract View: 2796 | Full Paper Download: 4057
Abstract View: 2796 | Full Paper Download: 4057
-
Produktivitas Budidaya Antara Bebek Peking (Anas platyrhynchos) dengan Bebek Hibrida (Anas platyrhynchos domesticus)
 DOI :
https://doi.org/10.36312/pjipst.v2i4.127
DOI :
https://doi.org/10.36312/pjipst.v2i4.127
 Abstract View: 3314 | Full Paper Download: 5003
Abstract View: 3314 | Full Paper Download: 5003
-
Ecolodge sebagai Implementasi Pendidikan Sains (IPA) yang Multidimensi
 DOI :
https://doi.org/10.36312/pjipst.v2i4.133
DOI :
https://doi.org/10.36312/pjipst.v2i4.133
 Abstract View: 394 | Full Paper Download: 528
Abstract View: 394 | Full Paper Download: 528